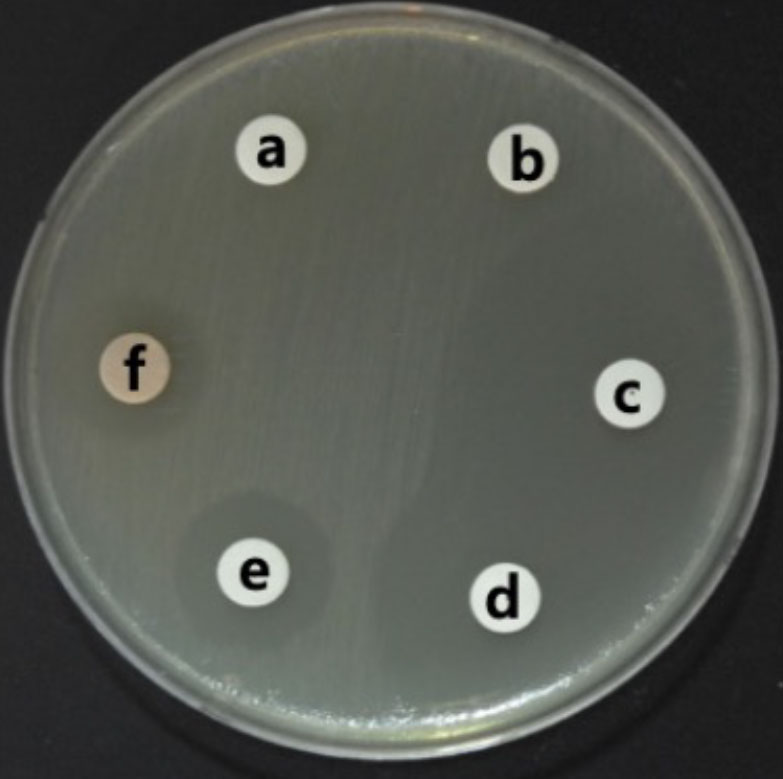
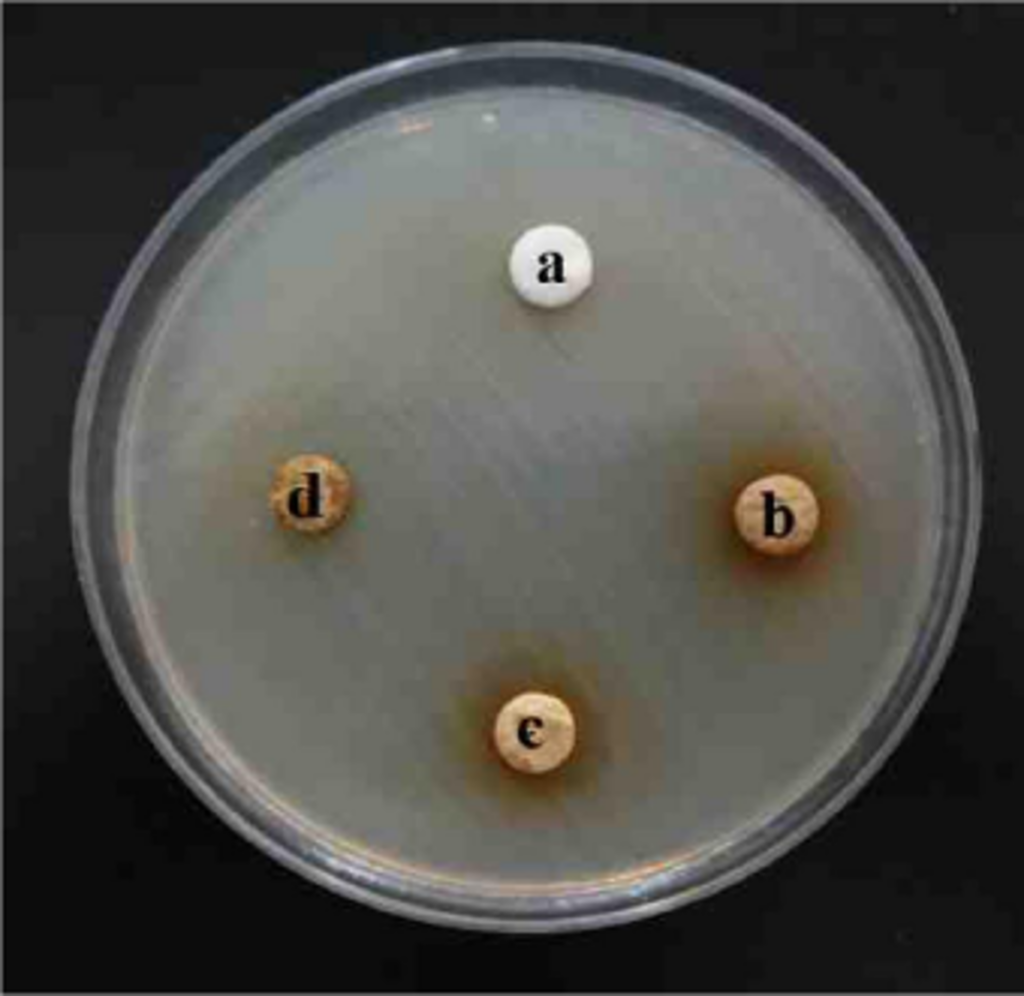

인체건강 유지 및 개선 기여 고기능성 바이오 소재 연구 및 개발
바이오소재
퓨어바이오는 인체의 건강 유지 및 개선에 기여하는 고기능성 바이오 소재의 연구 및 개발을 수행합니다.
천연물과 생리활성 물질을 기반으로 항산화, 면역 증진, 항염 등의 다양한 효과를 보유한 바이오 소재를 개발합니다.
그린바이오사업
청정원료
하동 청하원에서 재배하는 원료를 사용하여 원료를 개발합니다. 특히 노각나무추출물의 다양한 기능성 연구 개발과 자사 특허기술을 활용한 소재를 개발합니다.



AI 기반의 스마트팜 재배
무농약, 청정 소재를 활용한 스마트팜 재배 작물을 이용하여 원료를 표준화하고, AI를 도입한 스마트 재배를 통해 유효 물질을 부스팅합니다.



노각나무 소재 개발
노각나무추출물의 다양한 기능성 연구 개발 및 자사 특허기술을 활용한 소재 개발을 수행합니다.
노각나무의 특징
- 우리나라의 자생식물로 경상북도와 충청북도 이남의 표고 200∼1,200m에 자생
- 나무껍질에 얼룩무늬가 있어 비단나무 또는 금수목(錦繡木)이라고도 함.
- 내한성과 내음성이 강하여 나무 밑이나 그늘, 해변가에서도 잘 자라며 공해에도 잘 견딤
- 줄기와 뿌리의 껍질을 ‘모란(帽蘭)’이라 하여 근육과 힘줄을 풀고 혈행을 촉진하며 타박상과 풍습으로 인한 마비를 치료하는 약재로 씀
- 차나무과의 특성상 잎은 차(茶)로 활용되어 옴

노각나무 꽃

노각나무 잎

노각나무

노각나무
- 항산화
- 항염증
- 구강건강
- 항균활성
- 콜레스테롤 수치 개선
항산화 효과
노각나무잎은 강력한 항산화력을 갖고 있어, 피부 노화와 세포 손상을 예방하는 데 도움을 줍니다.
- 폴리페놀과 플라보노이드 풍부함
- 활성산소 제거 능력 우수함 → 잎 추출물은 가지보다 약 2배 높은 항산화력 보임
- ORAC 분석 기준, 비타민C 수준의 항산화 활성을 나타냄





| 함량 · 추출물명 | 노각나무 잎 | 노각나무 가지 |
|---|---|---|
| 총 폴리페놀 (mg GAEs/extract g) | 162.57 | 53.18 |
| 총 플라보노이드 (mg QEs/extract g) | 59.1 | 4.7å |
출처
Kim, H. S., Park, M. J., Kim, S. J., Kim, B. K., Park, J. H., Kim, D. H., & Cho, S. J. (2021).
Antioxidant Effects of Stewartia koreana Nakai Leaves and Branch Extracts. Journal of Life Science, 31(2), 229–236.
항염증
노각나무 추출물은 염증 유발 물질의 작용을 억제하여, 만성 염증 완화에 기여할 수 있습니다.




- 염증 유도 단백질(iNOS, COX-2) 발현 억제 확인됨
- 염증 매개물질(NO, PGE2) 생성 감소함
- NF-κB 신호전달 경로 억제 작용 확인됨
- 관절, 피부 등 다양한 조직의 염증 반응 완화 가능성 있음





출처
Lee, S.-S., Bang, M.-H., Park, S.-H., Chung, D.-K., & Yang, S.-A. (2018).
Inhibitory Effects of Flavonoids Isolated from the Leaves of Stewartia koreana on Nitric-oxide Production in LPS-stimulated RAW 264.7 Cells. Journal of Life Science, 28(5), 509–516.
Lee, T. H., Kwak, H. B., Kim, H. H., Lee, Z. H., Chung, D. K., Baek, N. I., & Kim, J. Y. (2007).
Methanol Extracts of Stewartia koreana Inhibit Cyclooxygenase-2 (COX-2) and Inducible Nitric Oxide Synthase (iNOS) Gene Expression by Blocking NF-κB Transactivation in LPS-activated RAW 264.7 Cells. Molecules and Cells, 23(3), 398–404.
구강건강
- 노각나무 잎 에탄올 추출물의 구강미생물 P. gingivalis KCTC5352에 대한 항균활성은 구강케어 제품인 triclosan과 유사한 항균활성을 나타냄.
- 양이온성 항균물질인 triclosan을 대체할 수 있는 천연물유래 구강건강소재로써 개발 가능성이 있음

- 노각나무 잎 에탄올 추출물은 P. gingivalis의 생육과 생물막 바이오매스 형성을 농도의존적으로 억제시킴.
- P. gingivalis에 대한 항균활성과 생물막 형성 억제 효과가 있는 천연물 유래 구강건강소재로써 개발가능성이 있음.
P. gingivalis KCTC5352에 대한 노각나무 잎 추출물의 최소성장억제농도(MIC) 및 최소살균농도(MBC)
| Concentration (mg/ml) | 0 | 0.2 | 0.4 | 0.6 | 0.8 | 1.0 | 2.0 |
|---|---|---|---|---|---|---|---|
| Minimum inhibitory concentration | +a | + | +/-c | –b | – | – | – |
| Minimum bactericidal concentration | + | + | + | + | + | + | + |
a, growth on test medium; b, no growth on test medium; c, slow growth on test medium.
- 노각나무 잎 에탄올 추출물의 MIC : 0.4 mg/ml
- 정균작용

- 노각나무 가지 에탄올 추출물이 P. gingicalis의 colony morpholog에 미치는 영향을 확인한 결과, 대조군에 비해 smoot한 형태 (주름X)로 관찰되었으며 이는 EPS가 감소되었음을 의미함.
- EPS는 다당류와 단백질, 지질, eDNA 등으로 구성되어있는 생체 고분자 혼합물로 그람 음성 세균의 세포사이에 공간을 만들고 바이오필름 매트릭스 구조를 형성하는데 관여함.
- 따라서, 노각나무 가지 추출물은 EPS 생성을 억제함으로써 P. aeruginosa의 colony morphology와 바이오필름 형성에 영향을 미침.
P. gingivalis에 대한 노각나무 가지 추출물의 최소성장억제농도(MIC) 및 최소살균농도(MBC)
| Concentration (mg/ml) | 0 | 0.2 | 0.4 | 0.6 | 0.8 | 1.0 | 2.0 |
|---|---|---|---|---|---|---|---|
| Minimum inhibitory concentration | Ga | G | G | Sc | NGb | NG | NG |
| Minimum bactericidal concentration | G | G | G | G | G | G | G |
Ga, growth on test medium; NGb, no growth on test medium; Sc, slow growth on test medium.
- 노각나무 가지 에탄올 추출물의 MIC : 0.6 mg/ml
- 정균작용

- 노각나무 가지 에탄올 추출물은 P. gingivalis의 생육과 생물막 바이오매스 형성을 농도의존적으로 억제시킴.
- P. gingivalis에 대한 항균활성과 생물막 형성 억제 효과가 있는 천연물 유래 구강건강소재로써 개발가능성이 있음.

- 노각나무 가지 에탄올 추출물을 처리하여 배양한 P.gingivalis를 주사전자현미경으로 관찰한 결과, 대조군에서 관찰된 EPS와 바이오필름이 관찰되지 않았음.
- P.gingivalis의 바이오필름 발달과 확산은 QS, EPS 및 c-di-GMP를 수반하는 다단계 프로세스에 의해 조절됨.
- 따라서, 노각나무 가지 추출물은 P.gingivalis의 바이오필름 발달과 확산에 관여하는 인자의 발현을 억제할 수 있는것으로 판단됨.
출처
Kim, H. S., Park, M. J., Kim, S. J., Kim, B. K., Park, J. H., Kim, D. H., & Cho, S. J. (2021).
Antibacterial and Antibiofilm Activities of Leaf Extracts of Stewartia koreana against Porphyromonas gingivalis. Journal of Life Science, 31(3), 330–337.
항균활성
- 노각나무 에탄올 추출물의 P. aeruginosa KACC14021에 대한 항균활성 측정 결과, 잎과 줄기 추출물이 항균활성을 나타냈으며 잎 추출물의 항균활성이 가장 우수하였음.

- 노각나무 잎 에탄올 추출물이 P. aeruginosa의 colony morphology에 미치는 영향을 확인한 결과, 대조군에 비해 smooth한 형태로 관찰되었으며 이는 EPS가 감소되었음을 의미함.
- EPS는 다당류와 단백질, 지질, eDNA 등으로 구성되어있는 생체 고분자 혼합물로 그람 음성 세균의 세포사이에 공간을 만들고 바이오필름 매트릭스 구조를 형성하는데 관여함.
- 따라서, 노각나무 잎 추출물은 EPS 생성을 억제함으로써 P. aeruginosa의 colony morphology와 바이오필름 형성에 영향을 미침.
P. aeruginosa에 대한 노각나무 잎 추출물의 최소성장억제농도(MIC) 및 최소살균농도(MBC)
| Concentration (mg/ml) | 0 | 0.2 | 0.4 | 0.6 | 0.8 | 1.0 | 2.0 |
|---|---|---|---|---|---|---|---|
| Minimum inhibitory concentration | +a | + | + | + | +/-b | –c | – |
| Minimum bactericidal concentration | + | + | + | + | + | + | + |
a, growth on test medium; b, no growth on test medium; c, slow growth on test medium.
- 노각나무 잎 에탄올 추출물의 MIC : 0.8 mg/ml
- 정균작용
출처
Lee, S. G., Kim, H. S., & Cho, S. J. (2023).
Inhibitory Effects of Stewartia koreana Extracts on Pseudomonas aeruginosa Biofilm Formation. Journal of Life Science, 33(11), 936–943.
콜레스테롤 수치 개선


- 노각나무 열매 추출물에서 분리한 (+)-카테킨의 농도가 증가함에 따라 PCSK9 수치가 억제되는 반면 LDLR 수치는 증가함.
- (+)-카테킨은 PCSK9 발현을 억제하고 LDLR 발현을 증가시키는 것으로 밝혀졌으며, 이는 (+)-카테킨이 PCSK9 발현의 하향 조절을 통해 콜레스테롤 수치를 낮출 수 있는 잠재력이 있음을 나타냄.
출처
Huh, J., Park, T. K., Chae, H. S., Nhoek, P., Kim, Y. M., An, C. Y., Lee, S., Kim, J., & Chin, Y. W. (2022).
Acylated saponins and flavonoid glycosides from the fruits of Stewartia koreana. Phytochemistry, 193, 112980.